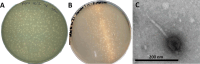
Fig 1

Complete genome sequences of StopSmel and Aussie, two Mu-like bacteriophages of Sinorhizobium meliloti
- PMID: 38385668
- PMCID: PMC10927670
- DOI: 10.1128/mra.01230-23
Complete genome sequences of StopSmel and Aussie, two Mu-like bacteriophages of Sinorhizobium meliloti
Abstract
We report the complete genome sequences of two bacteriophages, Aussie and StopSmel, isolated from soil using the host Sinorhizobium meliloti NRRL L-50. The genomes are similar in length and gene content and share 76% nucleotide identity. Comparative analysis of Aussie and StopSmel identified core functional modules associated with Mu-like bacteriophages.
Keywords: Mu-like bacteriophage; Sinorhizobium meliloti; agriculture.
Conflict of interest statement
The authors declare no conflict of interest.
Figures
References
-
- Galardini M, Mengoni A, Brilli M, Pini F, Fioravanti A, Lucas S, Lapidus A, Cheng JF, Goodwin L, Pitluck S, Land M, Hauser L, Woyke T, Mikhailova N, Ivanova N, Daligault H, Bruce D, Detter C, Tapia R, Han C, Teshima H, Mocali S, Bazzicalupo M, Biondi EG. 2011. Exploring the symbiotic pangenome of the nitrogen-fixing bacterium Sinorhizobium meliloti. BMC Genomics 12:235. doi:10.1186/1471-2164-12-235 - DOI - PMC - PubMed
Grants and funding
LinkOut - more resources
Full Text Sources
Research Materials

